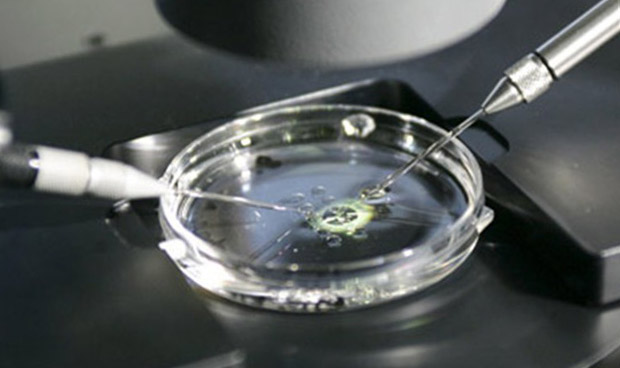

Las investigaciones realizadas hasta el momento no han conseguido explicar qué falló en el procedimiento para que la mujer recibiera semen equivocado.
El Tribunal Supremo ha condenado al Instituto Canario de Infertilidad a pagar 315.000 euros a una mujer inseminada con semen que no era de su pareja, sino de un donante del que se desconoce su identidad. Los hechos se remontan a 2007 cuando la mujer y su pareja recurrieron al tratamiento, ya que, este último no podía tener hijos por vía natural al estar vasectomizado. Tras el proceso, nacieron unos gemelos.
Según el medio que ha adelantado la noticia, Canarias 7, las investigaciones realizadas hasta el momento no han conseguido explicar qué falló en el procedimiento para que la mujer recibiera semen equivocado, ni tampoco permiten conocer quién es el verdadero padre.
Entre los motivos que esta mujer esgrimió para exigir la indemnización y que la justicia ha admitido, está la “angustia” que le produce no conocer quién es el verdadero padre biológico de sus hijos. El Supremo ha ratificado el fallo que en su día emitió la Audiencia Provincial de Las Palmas y desestimado el recurso que interpuso el centro médico.
El marido no dijo nada
El caso de esta mujer es complejo, ya que su ahora exmarido sí conoció que él no era el padre de los niños, pero lo silenció durante dos años. Poco después del alumbramiento, una enfermera le comunicó que él no podía ser el progenitor, puesto que el RH de los niños era negativo y el de ambos padres, positivo.
No fue hasta que en 2009 el matrimonio entró en crisis y comenzó el proceso de divorcio cuando el padre alegó que los hijos no eran suyos y que, por tanto, no debía pagar la cuota de mantenimiento familiar. Ante la sorpresa de la madre, las pruebas médicas confirmaron que ella era la única responsable legal de los niños. En medio de un proceso que la mujer ha descrito como “muy duro”, ésta decidió denunciar a la clínica.
 REGÍSTRATE GRATIS
REGÍSTRATE GRATIS
PARA SEGUIR LEYENDO
 ¿Ya eres premium? Inicia sesión
¿Ya eres premium? Inicia sesión

Aviso importante
El usuario desde el que está intentando acceder a este contenido no está registrado como profesional autorizado para acceder a esta información. Esta noticia informa sobre novedades farmacológicas y, por ley, está reservada a profesionales de la salud habilitados para la prescripción o dispensación de medicamentos.
Volver a la portada de Redacción Médica
Las informaciones publicadas en Redacción Médica contienen afirmaciones, datos y declaraciones procedentes de instituciones oficiales y profesionales sanitarios. No obstante, ante cualquier duda relacionada con su salud, consulte con su especialista sanitario correspondiente.